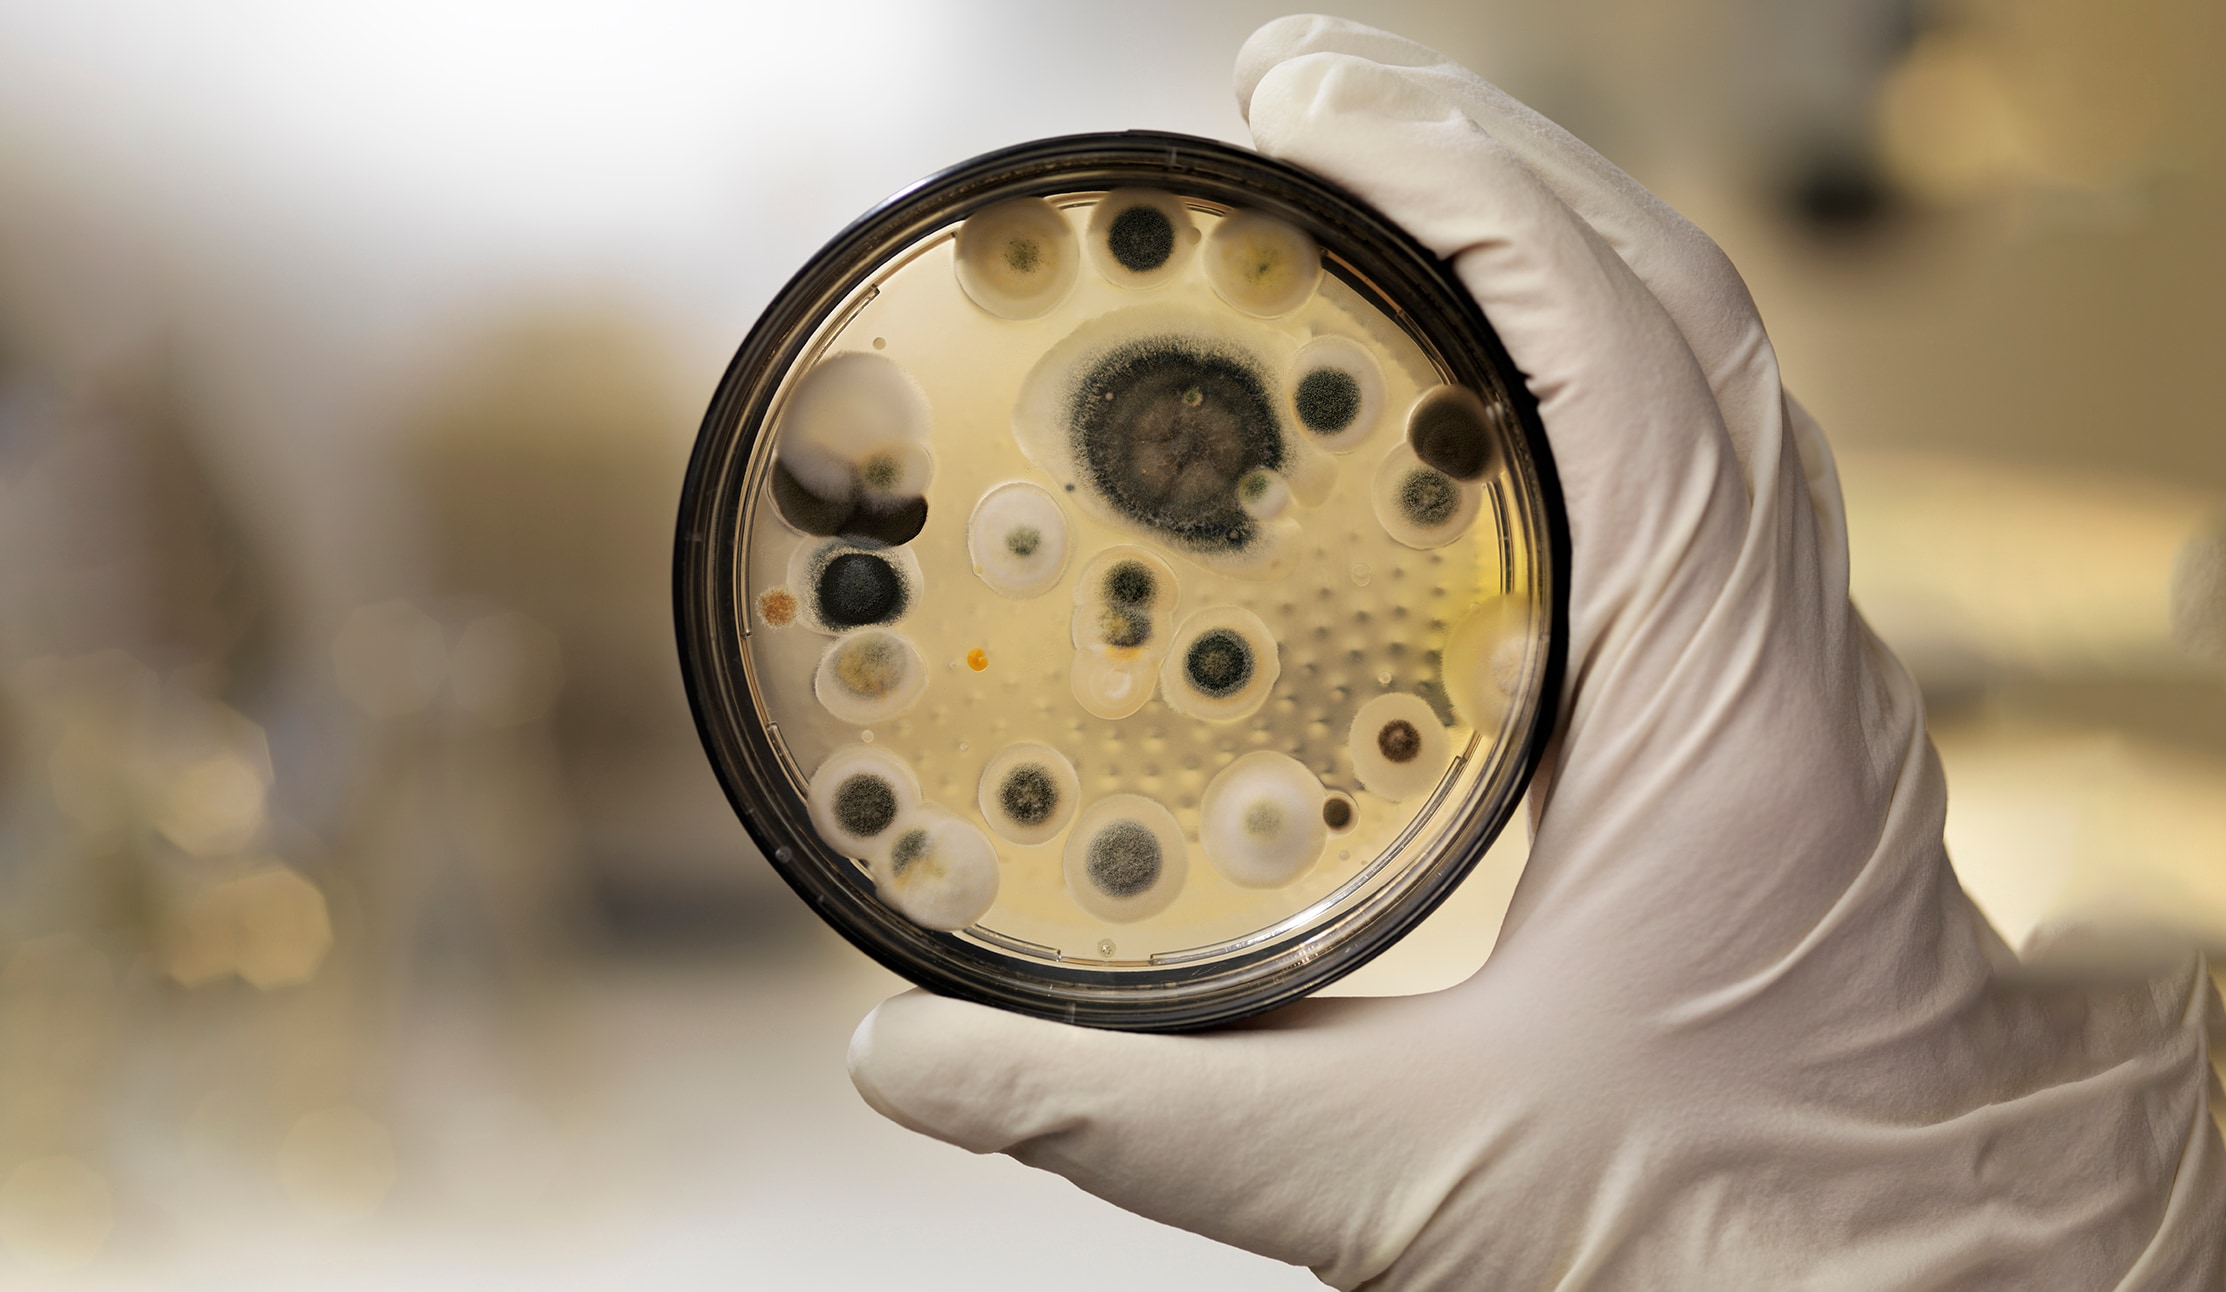
Aspergillus

Mold in Cleanrooms: A Persistent Threat and the Case for Proactive Bio-Decontamination
Cleanrooms are designed to be highly controlled environments where microbial contamination is minimized to protect sensitive processes, especially in pharmaceutical and biotechnological manufacturing. Yet, even in these rigorously maintained spaces, mold remains a persistent and insidious threat. The resilience, adaptability, and ability of mold spores to colonize hard-to-reach areas make them a formidable adversary in contamination control.
The Hidden Challenge of Mold in Controlled Environments
Mold thrives in warm, humid environments – conditions often found in walk-in incubators and other high-humidity zones found in cleanrooms. These areas, while essential for cell culture and microbial growth, inadvertently create ideal conditions for mold proliferation. The challenge is compounded by the complexity of equipment and infrastructure, such as mobile racking systems and HVAC ducting, which can harbor mold spores and facilitate their spread.
Even with stringent cleaning protocols in place, mold can persist and re-emerge, often from overlooked or inaccessible locations. This underscores a critical truth in contamination control: eradication must be absolute, or the problem is bound to return.
Case Study: A Persistent Mold Contamination in a Vaccine Manufacturing Facility
A multi-national vaccine manufacturer faced a recurring mold issue within a bank of walk-in incubators. Despite enhanced cleaning protocols, mold counts consistently reached actionable levels, prompting an urgent need for intervention.
Initial Response: Hydrogen Peroxide Vapor Bio-Decontamination
The facility engaged Ecolab’s Bioquell Rapid Bio-Decontamination Service (RBDS) to perform a targeted intervention. The Ecolab Bioquell bio-decontamination service was selected as it uses Bioquell HPV-AQ, a BPR approved biocide (Bioquell HPV-AQ 35% hydrogen peroxide approval written into European law – Biocidal Products Regulation (BPR, Regulation (EU) 528/2012)).
Each incubator was treated as a discrete enclosure, and hydrogen peroxide vapor was deployed overnight. Biological indicators (HPV-BIs) placed throughout the incubators confirmed that a 6-log sporicidal kill was achieved on exposed surfaces. Testing confirmed that bioburden levels dropped to zero post-treatment.
However, three months later, the same mold strain reappeared, an unexpected development but not unusual due to the persistence of mold. This time the results remained below actionable levels. Yet, the pattern persisted: full eradication followed by gradual recontamination.
Root Cause Investigation: Beyond the Surface
Recognizing the limitations of surface-level interventions, the microbiology team followed Ecolab’s recommendation to expand their investigation. Despite routine filter changes, the HVAC ducting was sampled and returned positive mold counts. This discovery was pivotal.
The target enclosure of the hydrogen peroxide vapor decontamination was broadened to include the surfaces within the HVAC ducting and adjacent storage rooms. Biological indicators were placed throughout these areas and confirmed successful bio-decontamination efforts. Following this comprehensive intervention, no mold counts were detected during the subsequent six-month production run, demonstrating the value in targeting HVAC surfaces as well as those within the incubator rooms.
From Reactive to Proactive: A New Standard in Mold Control
What began as a corrective action has now evolved into a proactive contamination control strategy. The vaccine manufacturer now performs automated bio-decontamination of their target enclosure (including incubators, HVAC surfaces and the associated storage areas) every six months. This approach has replaced traditional deep cleaning as the final step in post-shutdown recommissioning.
The gaseous nature of hydrogen peroxide vapor allows it to distribute into complex geometries and inaccessible areas and pass-through HEPA filters – an essential feature when dealing with mold, which can colonize in microscopic crevices and HVAC ductwork. The consistent success of this method highlights its value not just in remediation, but in prevention.
Conclusion: Mold Control Requires a Systems Approach
This case exemplifies a critical lesson for microbiologists and contamination control professionals: mold may not be able to be managed through surface cleaning alone. A systems-level approach – one that includes environmental mapping, root cause analysis, and comprehensive bio-decontamination – is essential.
Services like Ecolab’s Bioquell RBDS offer a fast, fully managed solution with detailed reporting, making them ideal for high-risk zones. By integrating such interventions into routine maintenance schedules, facilities can shift from reactive firefighting to proactive risk management – helping ensure critical manufacturing processes operate uninterrupted.



